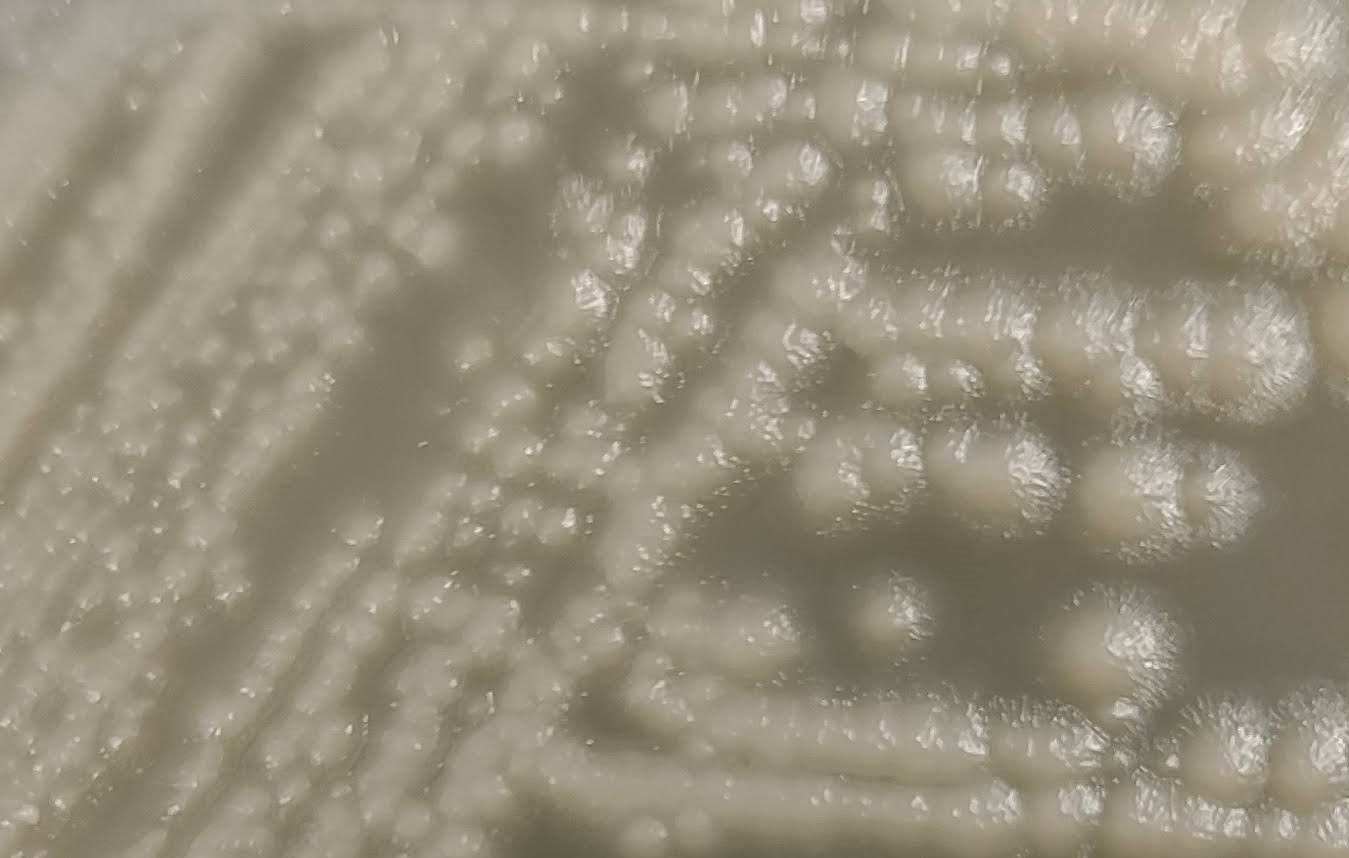
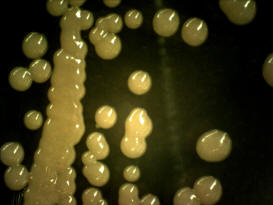
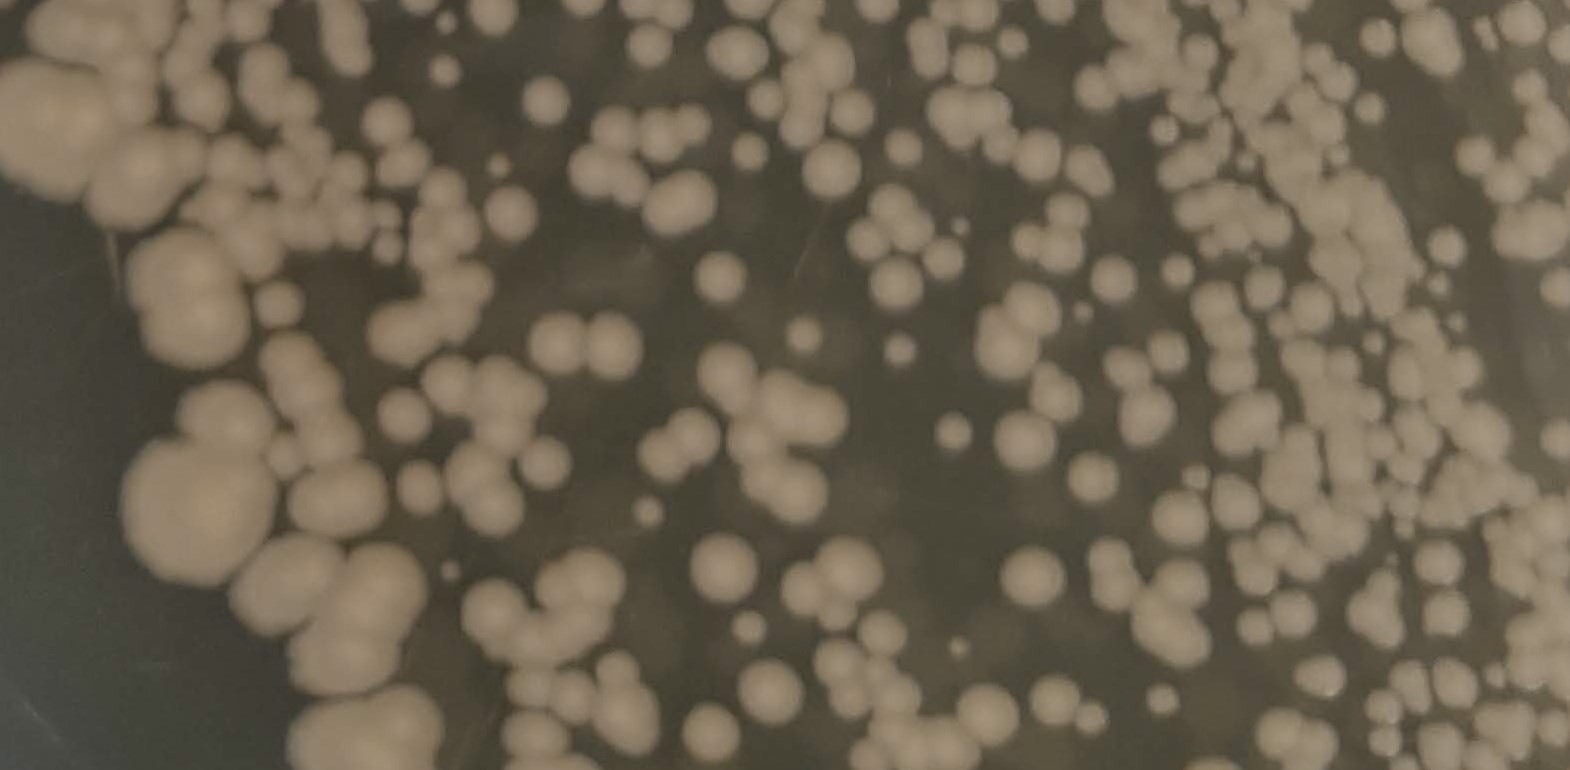
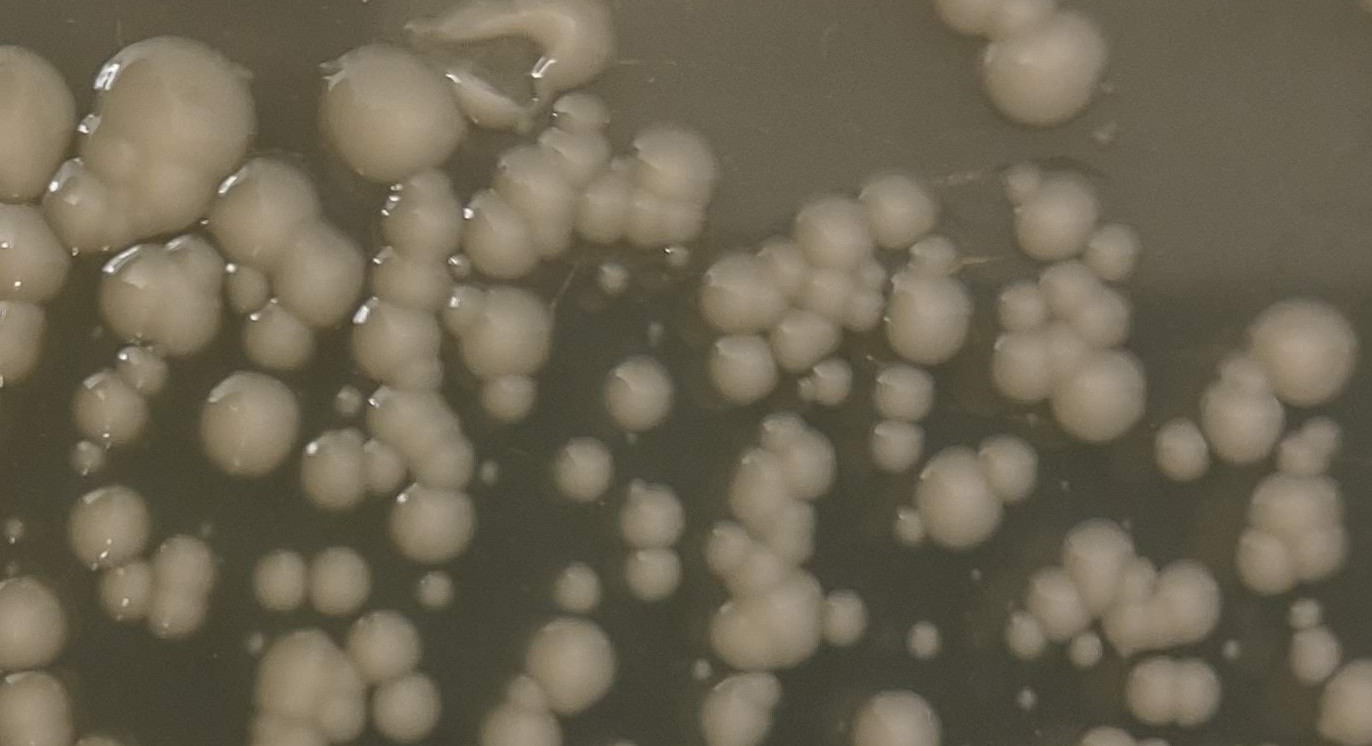
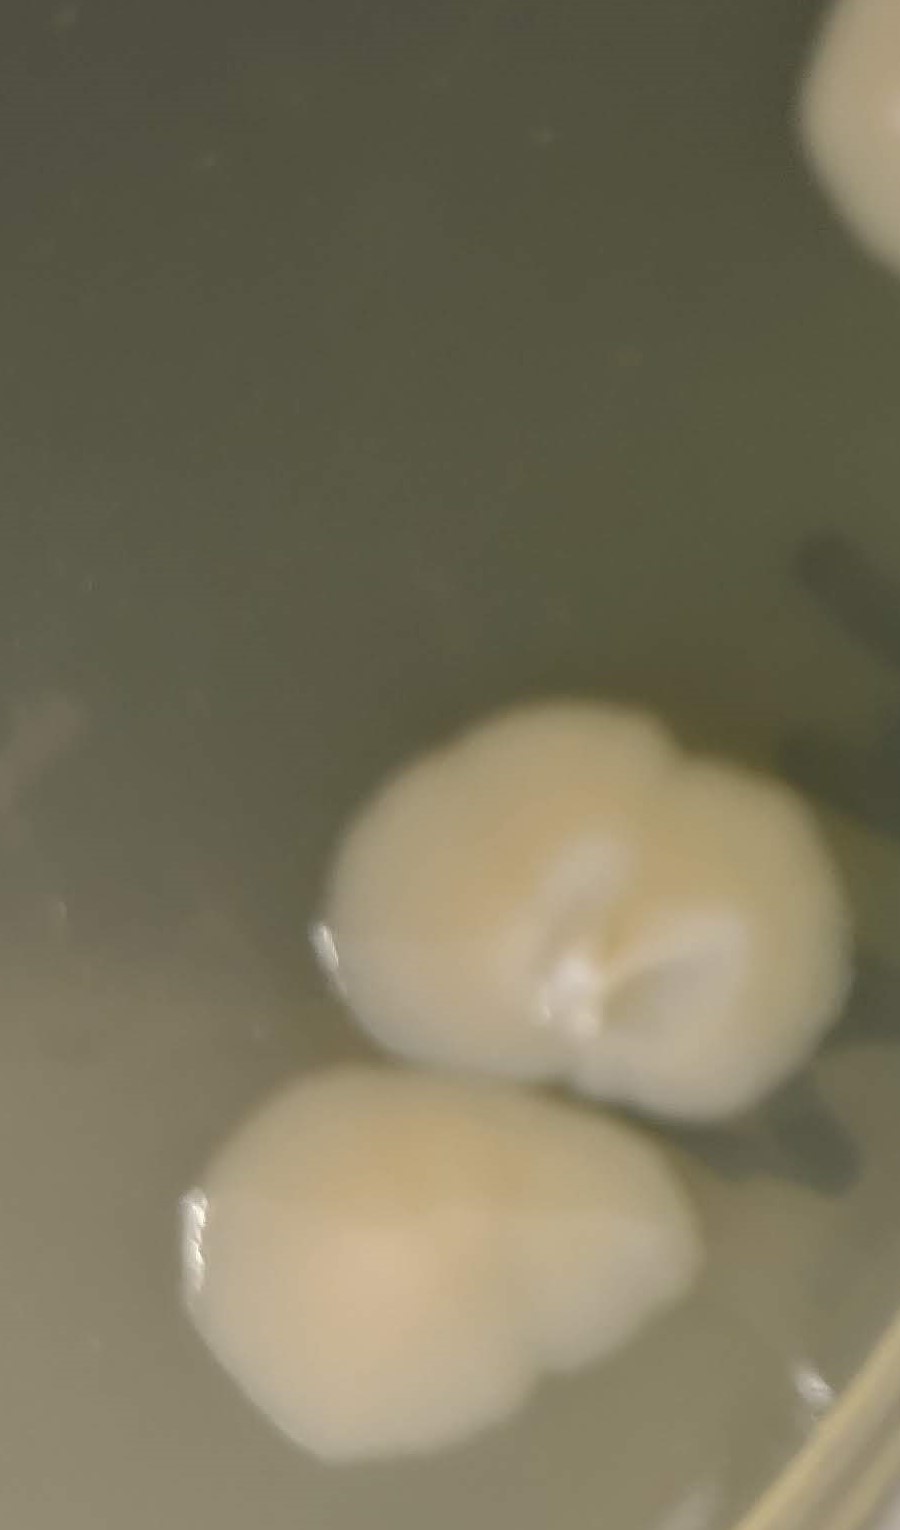
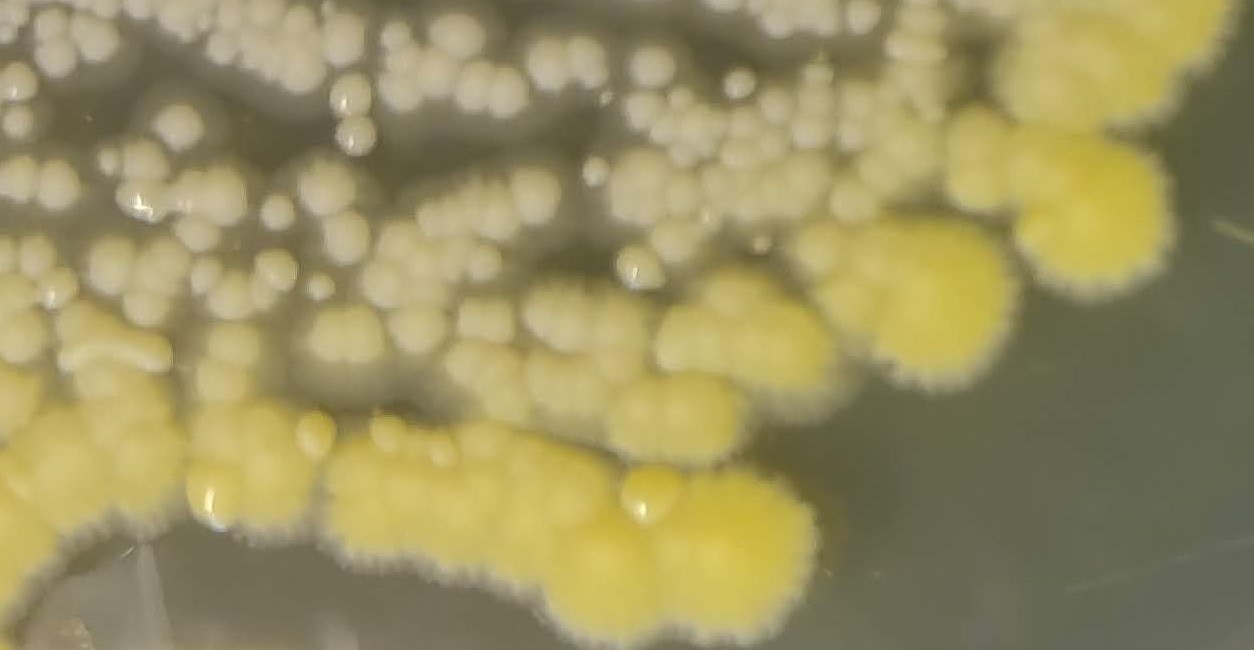
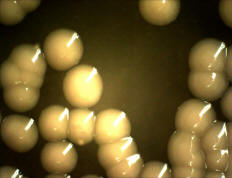
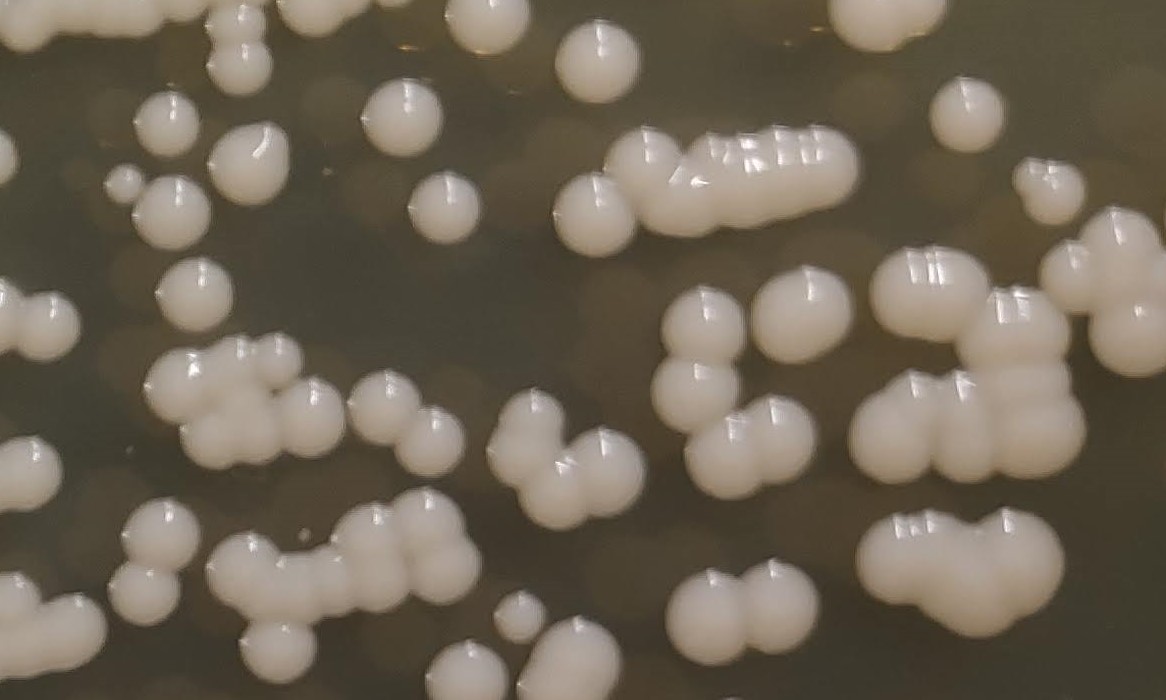
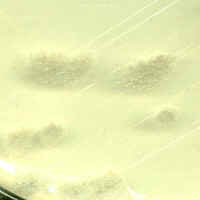
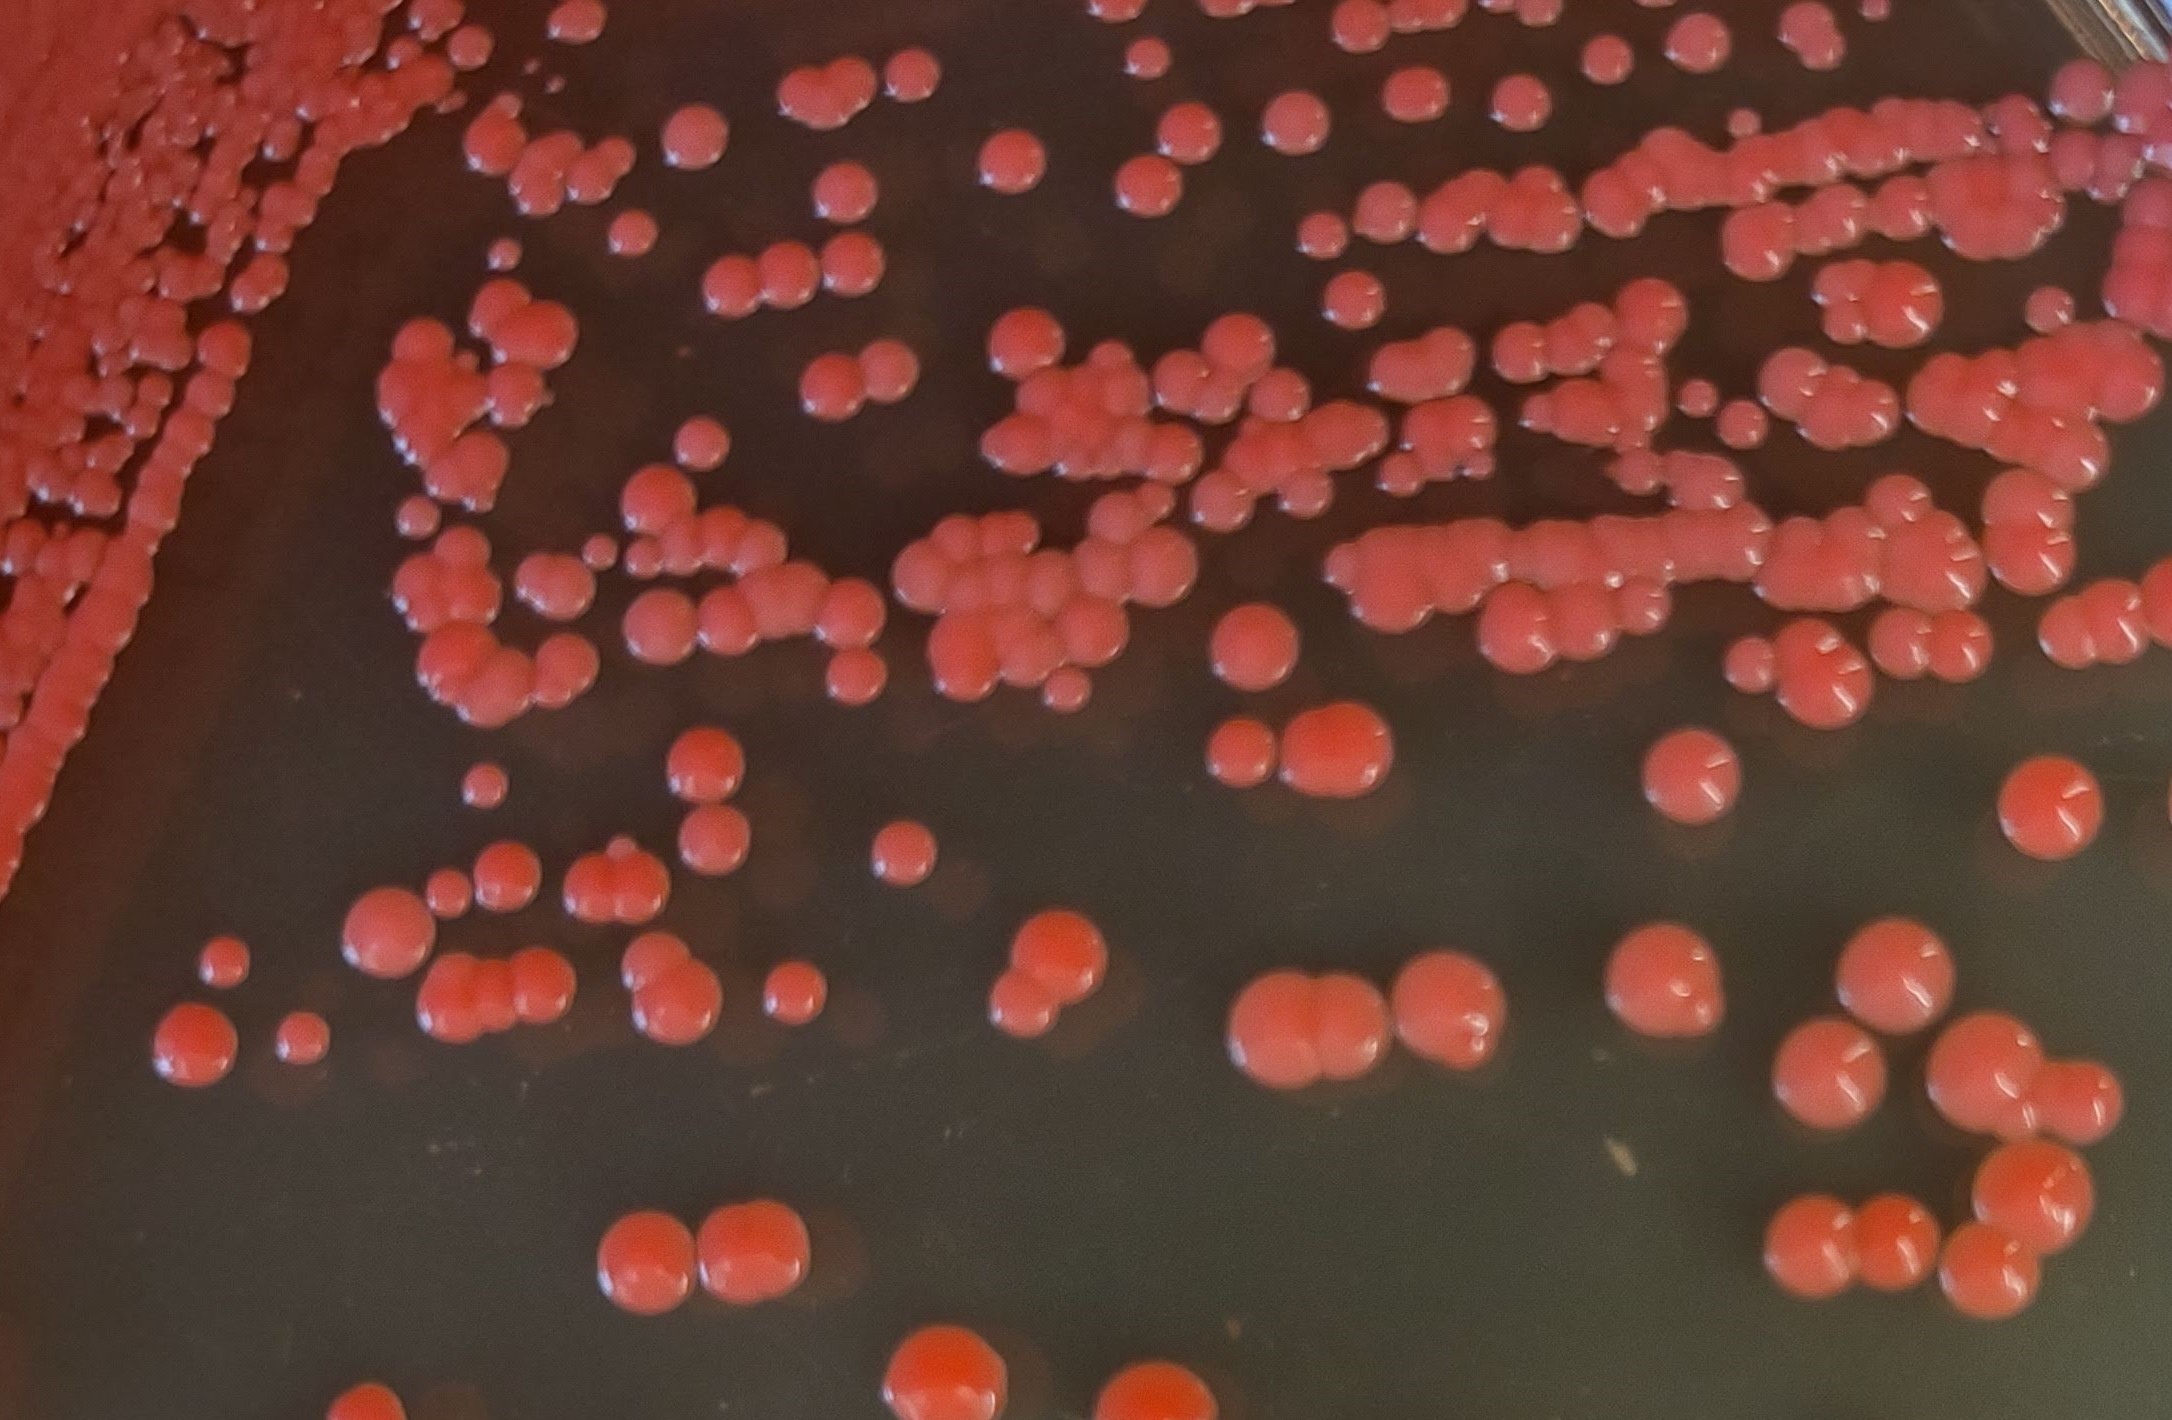
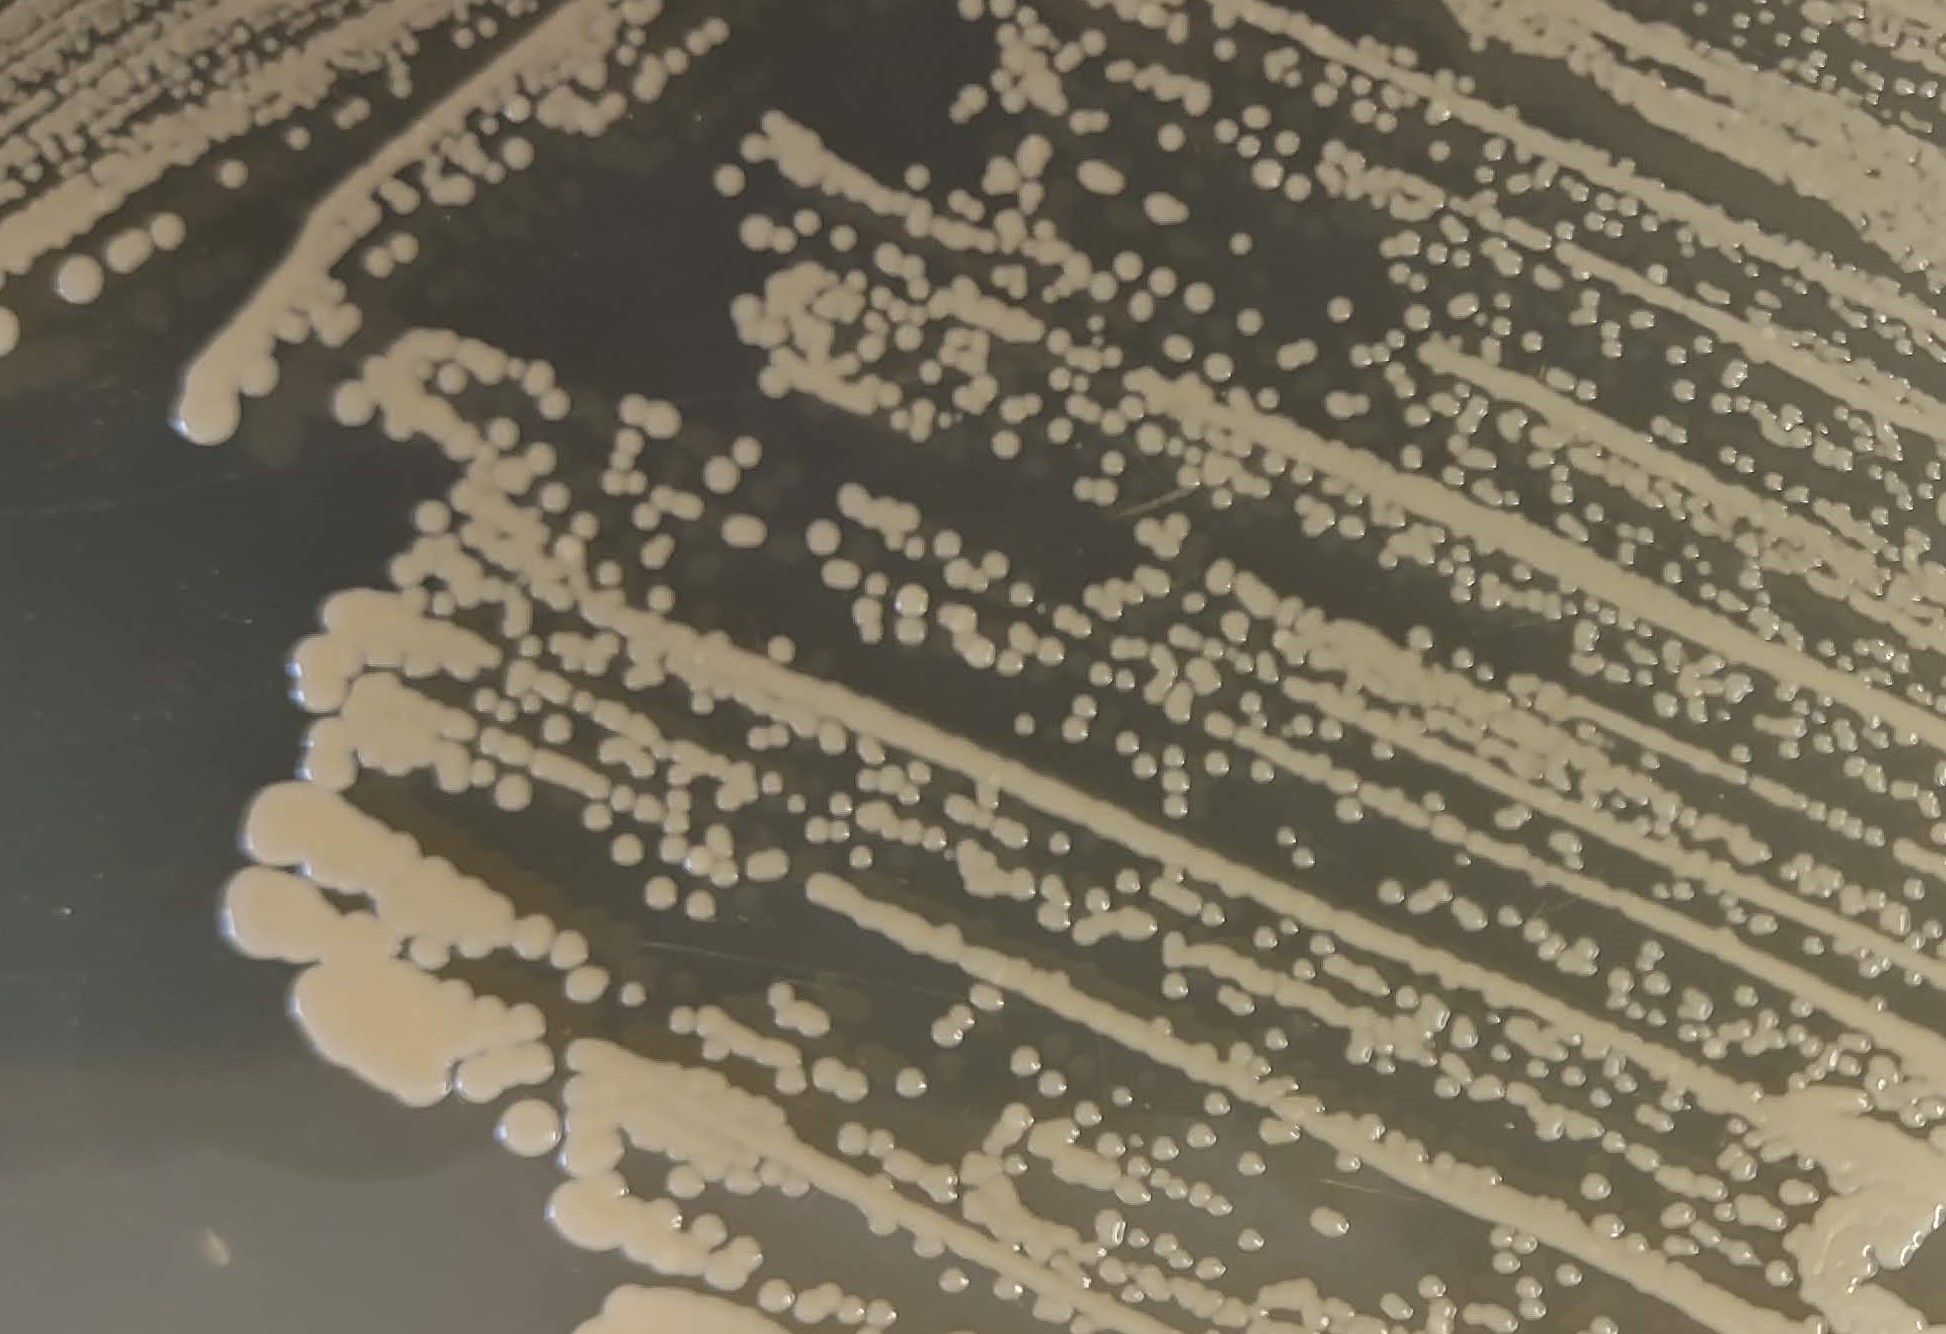
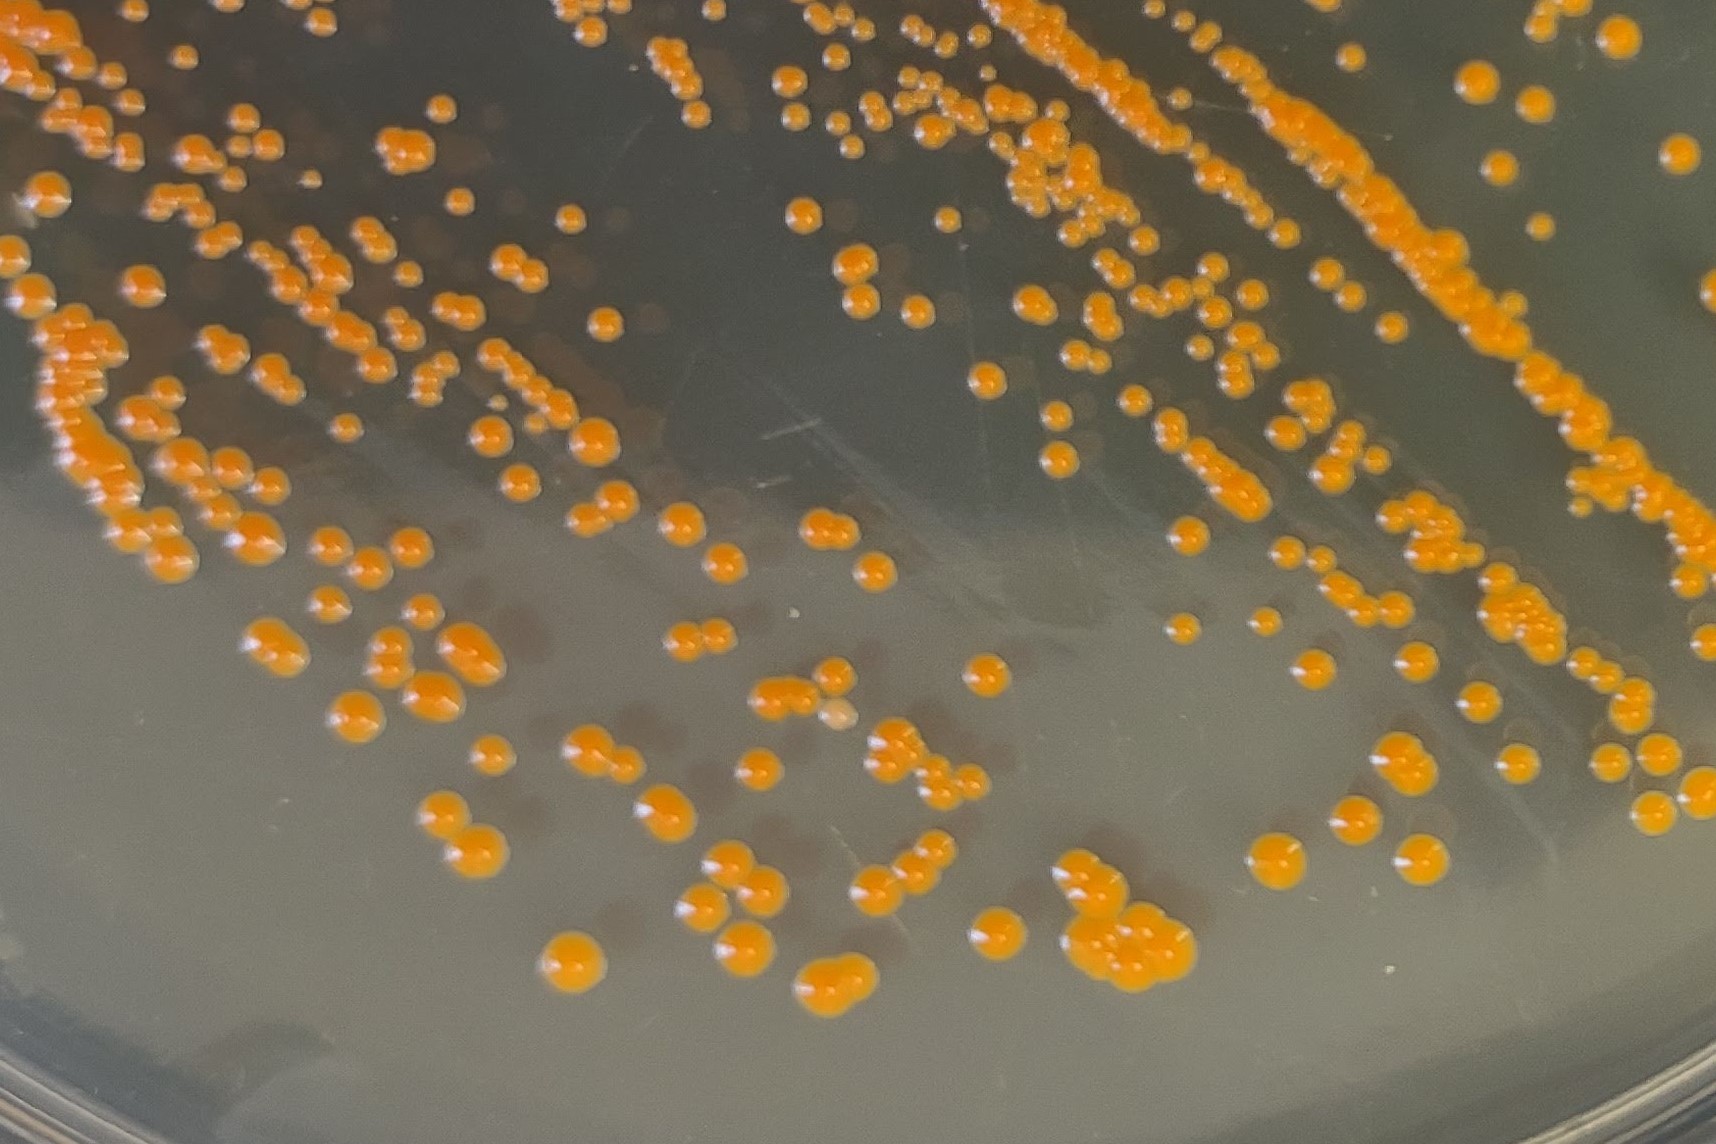
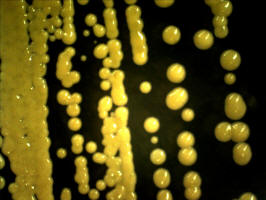
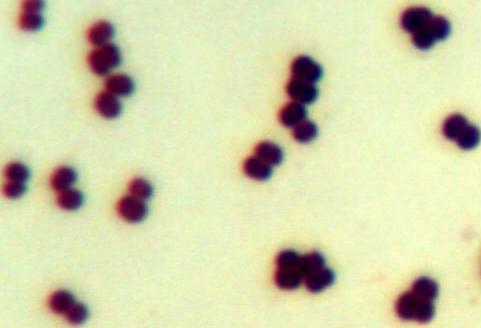

Acinetobacter spp.
|
 |
Red |
|
single rods 3 - 5 um long |
Aeromonas hydrophila
|
 |
White/beige |
 |
single rods 3 - 5 um long |
Alcaligenes faecalis
|
|
Off-white,
spreading edges, turning pink in center |
 |
single coccobacilli (short rods) 1 - 2 um long |
Branhamella catarrhalis
|
|
|
 |
paired cocci 1 - 2 um in diameter |
Chromobacterium violaceum
|
 |
Small,
opaque, purple |
 |
single rods 2 - 3 um in length |
Citrobacter freundii
|
 |
White/beige |
 |
single rods 2 - 3 um in length |
Edwardsiella tarda
|
 |
White,
flat |
.jpg) |
single rods 2-5 um in length |
Enterobacter cloacae
|
 |
White/beige |
|
single rods 2 - 3 um in length |
Escherichia coli (B)
|
|
White/beige |
 |
single rods 2 - 3 um in length |
Escherichia coli (K12)
|
 |
White/beige |
 |
single rods 2 - 3 um in length |
Klebsiella pneumoniae
|
|
White/beige |
 |
single rods 2 - 3 um in length |
Leclercia adecarboxylata
|
 |
White/beige/yellow |
 |
short rods 1 - 3 um in length |
Morganella morganii
|
|
White/beige |
 |
single rods 2 - 3 um in length |
Neisseria perflava & sicca
|
 |
White/beige |
 |
paired cocci 1 um in diameter |
|
Paracoccus caroteum |
.jpg) |
Orange |
|
|
Proteus vulgaris
|
 |
White/beige,
swarming |
 |
single rods 2 - 3 um in length |
Providencia alcalifaciens
|
 |
White/beige |
 |
single rods 2 - 3 um in length |
Pseudomonas aeruginosa
|
.jpg) |
White/beige,
spreading edges, turn pink as they get older |
 |
single rods 2 - 4 um in length |
Pseudomonas fluorescens
|
 |
White/beige |
|
single rods 2 - 3 um in length |
Pseudomonas putida
|
|
Small,
pale yellow |
 |
single rods 2 - 3 um in length |
Rhizobium leguminasorum
|
| |
Beige/white |
 |
single rods 2 - 3 um in length |
Rhodospirillum rubrum
|
 |
Small
red, grow slowly |
  |
in young cultures, cells are curved (vibrio) and 2 - 4 um
long. As they get older, long spirals (10 - 20 um) may be seen as well |
|
|
|
|
Serratia liquefaciens
|
|
White/beige |
 |
single rods 2 - 3 um in length |
Serratia marcesens
|
 |
Red/orange |
 |
single rods 2 - 3 um in length |
Shigella dysenteriae
|
 |
White/beige |
 |
single rods 2 - 3 um in length |
Stentrophomonas maltophila
|
 |
White/beige |
 |
single rods 2 - 5 um in length |
Vibrio natriegens & angularis
|
 |
White/beige |
 |
single rods 2 - 3 um in length |
Vibrio parahaemolyticus
|
 |
White/beige |
 |
single rods or curved cells 2 - 3 um in length |
Yersinia enterocolitica
|
 |
White/beige |
 |
single rods 2 - 3 um in length |
Gram-positive bacteria
|
Arthrobacter globiformis
|
 |
Opaque white colonies |
|
Irregular rods 3 - 5 um |
Actinomyces spp.
|
 |
Small, dry, powdery white colonies |
 |
Filamentous rods, branching; Spores may be present |
|
|
|
|
|
Bacillus cereus
|
 |
Large
flat white |
 |
rod-shaped cells, 3 - 5 um long, in chains; endospores may
be visible |
Bacillus mycoides
|
 |
White
opaque with rhizoid edges |
 |
rod-shaped cells, 2 - 4 um long, in chains; endospores may
be visible |
Bacillus subtilis
|
 |
large
white flat and opaque |
 |
rod-shaped cells, 3 - 5 um long, in chains; endospores may
be visible |
Clostridium sporogenes
|
|
white
opaque with rhizoid edges |
|
single rod-shaped cells; endospores may be present |
Corynebacterium pseudodip.
|
 |
Beige,
small and opaque |
 |
irregular (club-shaped) rods, 2 - 3 um long, often in
parallel (palisade) arrangements or V-shapes |
Deinococcus radiophilus
|
 |
Shiny orange-reddish colonies |
|
large cocci in tetrads |
Enterococcus faecalis
|
 |
Small
white |
 |
round or oval cocci, 1 um in diameter, forming pairs or
short chains |
Kurthia gibsonii
|
 |
White/Beige
opaque |
 |
regular-shaped rods, 2 - 4 um long, in pairs or short chains |
Lactobacillus acidophilus
|
| |
Small
white |
 |
single rods, 2 - 3 um long |
Lactobacillus plantarum
|
 |
Small white |
 |
single rods, 2 - 3 um long |
Leuconostoc mesenteroides
|
 |
translucent white colonies |
 |
chains of cocci 1 um in diameter |
Listeria monocytogenes
|
 |
Small translucent white colonies |
 |
single rods, 2 - 3 um long |
Micrococcus agilis
|
|
Small
red |
 |
cocci 1 - 2 um in diameter, in regular clusters, esp.
tetrads |
Micrococcus luteus
|
 |
Small
pale yellow |
 |
cocci 1 - 2 um in diameter, in regular clusters, esp.
tetrads |
MIcrococcus lysodeitikus
|
|
Medium sized beige colonies |
 |
clusters/tetrads of cocci 1 - 2 um in diameter |
Micrococcus nishyominensis
|
|
orange/red |
 |
cocci 1 - 2 um in diameter, in regular clusters, esp.
tetrads |
Kocuria roseus
|
 |
Small
pink |
 |
cocci 1 - 2 um in diameter, in regular clusters, esp.
tetrads |
Mycobacterium phlei
|
 |
Small
crumbly/dry white/beige |
 |
thin rods, 3 - 5 um long, often clumped into filaments |
Nocardia corallina
|
.jpg) |
Small white powder colonies |
 |
branching filaments (hyphae) |
Pediococcus damnosus
|
 |
Small white |
 |
cocci, often clumped or in tetrads |
Paenibacillus polymyxa
|
 |
flat white |
 |
long thin rods, 3 - 5 um; spores and endospores may be
present |
Sarcina auriantiaca
|
 |
orange/yellow |
 |
cocci in tetrads |
Sporosarcina ureae
|
|
Dark
yellow, small |
|
cocci, 1 um in diamater, clumped into tetrads |
Staphylococcus aureus
|
.jpg) |
Yellow/golden |
 |
cocci, 1 um in diameter, in irregular clusters |
Staphylococcus epidermis
|
 |
White |
 |
cocci, 1 um in diameter, in irregular clusters |
Staphylococcus saprophyticus
|
 |
White |
 |
cocci, 1 um in diameter, in irregular clusters |
Staphylococcus xerosis
|
 |
golden yellow |
 |
cocci, 1-2 um in diameter, in irregular clusters |
Streptococcus lactis
|
 |
Small
white |
 |
cocci (oval or round) in short or long chains |
Streptococcus pyogenes
|
 |
Small white |
 |
oval or round cocci, 1 um in diameter, often in long chains |
Streptococcus thermophilus
|
| |
Small
white |
 |
cocci (oval or round) in short or long chains |
Streptomyces antibioticus
|
 |
Powdery/filamentous white |
 |
branching filaments |